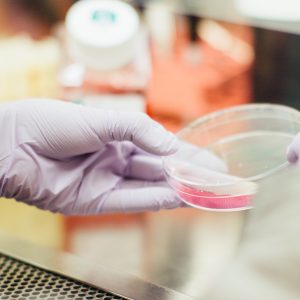
gloved hands holding petri dish

Could Cancer Immunotherapy Success Depend on Gut Bacteria?
UT Southwestern Medical Center via EurekAlert- Could the response to cancer immunotherapy depend on bacteria that originate in the gut and travel to the tumor? DALLAS – March 6, 2020…
Heart Attack Risk: Loneliness Is Worse Than Smoking?
Dr. Don Colbert – Loneliness is an increasing, serious problem in modern society with serious health and mortality consequences similar to smoking cigarettes. But we have power through God to…
When Should You Eat to Manage Your Weight? Breakfast, Not Late-Night Snacks
PLOS via Newswise – The balance between weight gain and weight gain loss is predominantly determined by what you eat, how much you eat, and by how much exercise you…
A New AI ‘Super Nurse’ Monitors Patients in Israeli Hospital
Brian Blum via Israel21c – Artificial intelligence can spot potential deterioration before a human nurse or doctor could, and it can predict which patients will be readmitted. Look, it’s Super…
DNA Discovery Can Lead to New Types of Cancer Drugs
University of Copenhagen the Faculty of Health and Medical Sciences via EurekAlert – Cells can both survive and multiply under more stress than previously thought, shows research from the Faculty…
Proof that Lifelong Cholesterol Reduction Prevents Heart Disease
Michael Greger M.D. FACLM via Nutrition Facts – “It is well accepted that coronary atherosclerosis is a chronic progressive disease that begins early in life and slowly progresses over several…
Effects of Tobacco on the Immune System
Osman Shabir, M.Sc. via News-Medical Net – Smoking is one of the leading causes of preventable deaths and illnesses within the USA, with approximately 480,000 people within the USA dying…
Researchers Announce Progress in Developing an Accurate, Noninvasive Urine Test for Prostate Cancer
Johns Hopkins Medicine via EurekAlert – Researchers at the Johns Hopkins Kimmel Cancer Center have made significant progress toward development of a simple, noninvasive liquid biopsy test that detects prostate…
Osteoarthritis: How Running Actually Can Help
LifeBridge Health via Newswise – Not running or jogging because you think it worsens or increases your risk for osteoarthritis? You may be skipping a form of exercise that can…
Expert Who Studies History of Epidemics: ‘Panic May Be the Worst Possible Response’
Virginia Tech via Newswise – A Virginia Tech professor who studies the history of international epidemics says the United States “should look to history for guidance on how to interpret…
Fatty Fish Protect Against Type II Diabetes
Sarah Moore via News-Medical Net – A new study has revealed that the environmental pollutants that contaminate the fish we consume stop them from protecting us from type 2 diabetes.…
Eating a Vegetarian Diet Rich in Nuts, Vegetables, Soy Linked to Lower Stroke Risk
American Academy of Neurology (AAN) via Newswise – “Stroke is the second most common cause of death worldwide and a leading cause of disability…” Newswise — MINNEAPOLIS – People who…
New Compounds May Help Stop the Spread of the Coronavirus
Angela Betsaida B. Laguipo, BSN via News-Medical Net – Amid the global health crisis of the coronavirus (COVID-19), scientists from around the world are racing to find a treatment to…
Two Sides of a Coin: Our Own Immune Cells Damage the Integrity of the Blood-Brain Barrier
Nagoya University via EurekAlert – The blood-brain barrier is a layer of cells that covers the blood vessels in the brain and regulates the entry of molecules from the blood…
What to Eat & What Not to Eat for Optimal Mental and Brain Health According to a Nutritional Psychiatrist
Dr. Caroline Leaf – How you think affects how you eat, because the food you eat is determined by your specific choices and desires. But did you know that what…